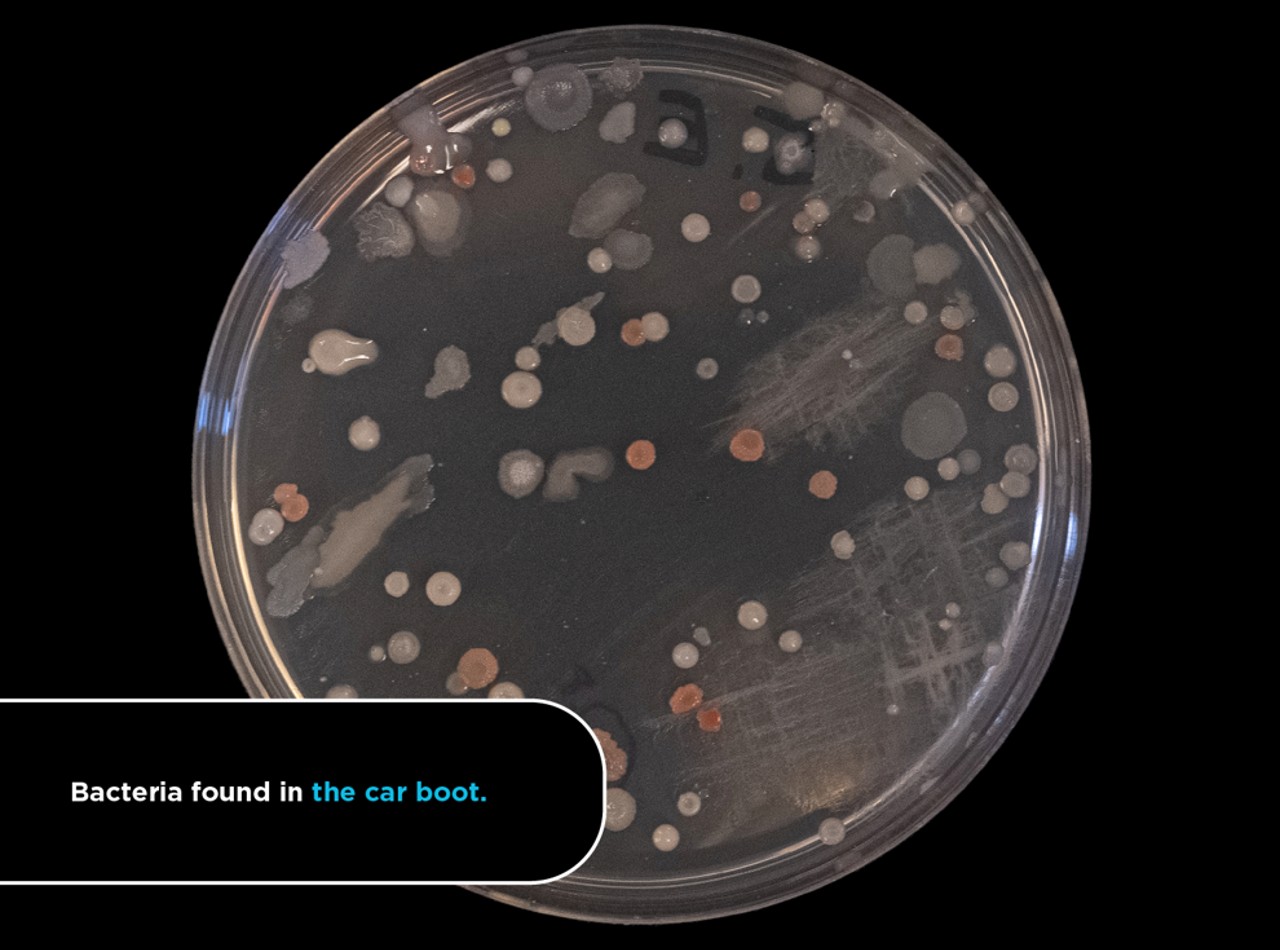
interior coche sucio inodoro
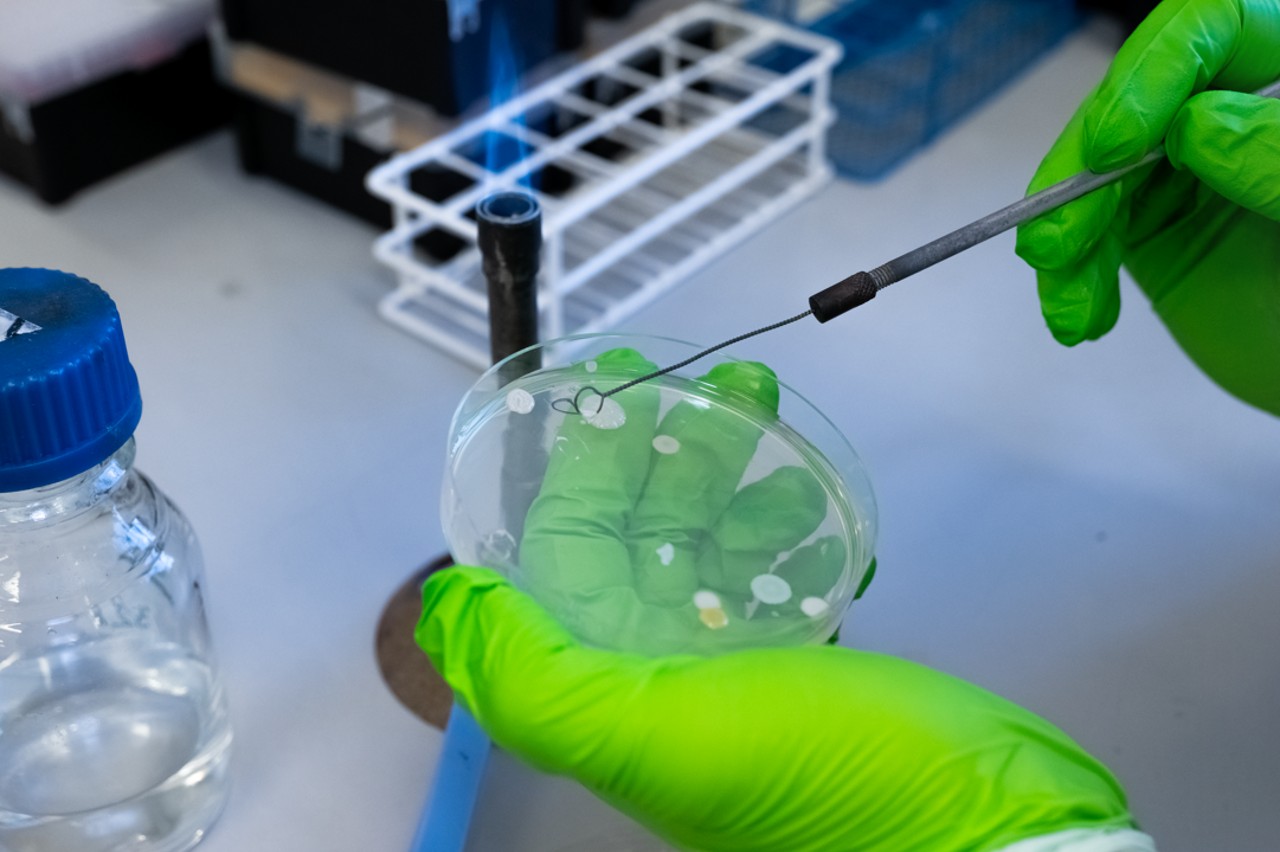
interior coche sucio inodoro

La limpieza es una parte muy importante del mantenimiento de un vehículo, aunque hay mucha gente que no parece preocuparle tener su coche lleno de suciedad. Sin embargo, puede que, a partir de ahora, acudan al lavadero más cercano cada semana. Según un estudio, el interior de los coches es más sucio que un inodoro. Tal cual.
El estudio ha sido encargado por Scrap Car Comparison y realizado por investigadores de la Escuela de Biociencias de la Universidad de Aston, en Reino Unido. Tras analizar las muestras de dos inodoros y cinco vehículos, encontraron altos niveles de bacterias fecales en los coches, incluso en uno que solo tenía dos años de vida.
El interior de los coches es más sucios que un inodoro
Los resultados de esta investigación pueden revolverle el estómago a más de uno. Los coches analizados contenían altos niveles de bacterias fecales, especialmente, en el maletero, justo el espacio donde la mayoría de la gente transporta los alimentos cuando van al supermercado a hacer la compra.
Las bacterias fecales también estaban presentes en el asiento del conductor, algo que es menos sorprendente. Sabiendo esto, es posible que ya no te comas esa patata frita que se te ha caído en el asiento. Los coches analizados fueron un Peugeot 307 SW con 17 años, un Volkswagen Golf con cinco años, un Ford Focus de 13 años, un Honda Jazz con nueve años y un Peugeot 308 con solo dos años.
El maletero, el lugar más sucio del coche
El maletero es el jugar más sucio del coche, según los resultados del estudio de la universidad británica, con 1.425 bacterias como E.coli encontradas. Le sigue el asiento del conductor, con 649 bacterias, la palanca de cambios, con 407 bacterias, el asiento trasero, con 323 bacterias, y el salpicadero, con 317 bacterias.
Curiosamente, una de las zonas más limpias en los coches es el volante. Sorprende porque es donde pasan manos tiempo las manos del conductor, pero los investigadores sostienen que esto se debe al uso intensivo de geles hidroalcohólicos en los últimos tiempos, por la pandemia.
En definitiva, el estudio demuestra que debemos preocuparnos más por la limpieza e higiene de nuestro coche. Lógicamente, cuanto más viejo es un vehículo, más bacterias puede tener. No obstante, como señala el doctor Jonathan Cox, “no tenemos que preocuparnos demasiado, simplemente la gente debe ser consciente de que no toda la suciedad es visible y hacer un mayor esfuerzo para mantener limpios sus coches para evitar enfermedades”.









